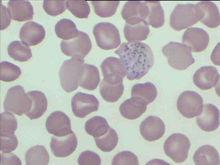
相關圖片

犬巴貝斯焦蟲
 巴貝斯焦蟲
巴貝斯焦蟲入夏以來,不少養狗族都喜歡帶著愛犬去爬山鍛鍊或郊遊。但是,當狗狗在山上追蹤尋樂時,一種在山林中潛伏的“吸血鬼”正悄悄地伺機爬上狗狗的身體。這種名為“ 巴貝斯蟲”的病會導致狗嚴重貧血,最終死亡,而治療最有效的辦法就是輸血。
目前救治的辦法除了要殺蟲外就是給狗輸血。狗輸血不像人那樣需要嚴格配血型,一般第一次給狗輸血只要進行一個交叉試驗,若沒有異常反應,就可以進行輸血。
巴貝斯蟲是一種 寄生蟲,是通過一種叫做“ 蜱”的小動物傳染給狗的(在河南也有通過鬥狗相互傳播)蜱是一種會吸狗血的小昆蟲,平時常在山上草木叢生的地方生存。狗被蜱叮咬後,一方面要被蜱吸血,另一方面還會得巴貝斯蟲病。不過,蜱對人血卻毫無“興趣”,也不寄生於人體。
相關圖片
相關圖片巴貝斯蟲病是一種經硬蜱傳播的血液原蟲病,呈全球性分布。
病原及其生活史
犬巴貝斯蟲病的病原有3種:
 犬巴貝斯焦蟲
犬巴貝斯焦蟲(1)犬巴貝斯蟲:蟲體較大,一般長4~5微米,最長可達 7微米。典型蟲體為 雙梨籽形,兩蟲尖端以銳角相 連,每個紅細胞內的蟲體數目為1~16個。
(2)吉氏巴貝斯蟲:蟲體很小,多呈環形。卵為圓形,呈梨籽形的很少。一個紅細胞內最多可寄生30個蟲體。
(3)韋氏巴貝斯蟲:除體形略大外,形態與犬巴貝斯蟲相似。
犬巴貝斯蟲的傳播媒介為血紅扇頭蜱、邊緣革蜱、網紋革蜱、美麗革蜱、李氏血蜱和鉛色璃眼蜱;吉氏巴貝斯蟲的傳播媒介為血紅扇頭蜱、二棘血蜱和長角血蜱。兩種巴貝斯蟲都可經卵傳遞,也可經變態階段傳遞。
診斷要點
(1)流行病學調查:當地是否有傳播本病的蜱,當時是否為蜱的活動季節。病犬是否有遭到蜱叮咬的病史或在其體上抓到過蜱。
(2)臨床症狀:犬巴貝斯蟲病,主要表現為 高熱,黃疸,呼吸困難。有些病犬 脾臟腫大,觸之敏感。尿中含蛋白質,間或含血紅蛋白。吉氏巴貝斯蟲病常呈慢性經過,僅病初發熱或為間歇熱。病犬高度貧血,但無黃疽。雖食慾良好,卻高度消瘦,尿含蛋白質或兼有微量的血紅蛋白。病犬常死於衰竭。
(3)實驗室檢查:采病犬耳尖血作塗片,姬氏液染色後檢查,如發現典型蟲體即可確診。
治 療
套用三氮脒(貝尼爾、血蟲淨),用量為3.5毫克/千克體重,皮下或肌肉注射,每天1次,連用兩天。或用咪唑苯脲,用量為5毫克/千克體重,1次皮下或肌肉注射或間隔24小時再用1次,或每千克體重用5~7毫克肌肉注射,間隔14天再用1次。
【預 防】可以選用以下幾種方法;
(1)建議定期使用體外驅蟲藥給狗狗驅蟲(需選擇具有驅蜱作用的體外驅蟲藥)。
(2)在疫區,要做好犬體的防蜱滅蜱工作。可套用殺蟲藥,如 25ppm溴氰菊酯溶液,每隔7~10天噴淋1次犬體。
(3)對病犬應做到早發現,早診斷,早治療。發現病例後,可套用 三氮脒、咪唑苯脲的治療劑量對其他健康犬進行藥物預防
綜合防制措施
控制或禁止犬到有蜱活動的疫區活動,切斷蜱傳播鏈。在非疫區對易感犬每年2次預防性注射抗原蟲特效藥;在疫區除了對犬進行預防性注射外,用體外驅蟲藥給犬進行全身藥浴;對犬舍、蜱棲息的環境徹底噴淋驅蟲藥驅殺蜱。?
有資料顯示,本病還可以通過胎盤垂直傳播。本病痊癒後的母犬近期(1年內)再次發情、交配、懷孕時,即使處在健康帶蟲狀態,也有可能通過胎盤不同程度地垂直傳播給仔犬。患病期母犬受孕分娩後,所生仔犬均可能受到感染,並呈現貧血,造成各組織器官缺氧,還可直接使仔犬致死。如果給患犬注射感染吉氏巴貝斯蟲病康復犬的血清,可使其臨床症狀不明顯。所以,在疫區給成年生育期母犬免疫是一項極為重要的預防措施。
